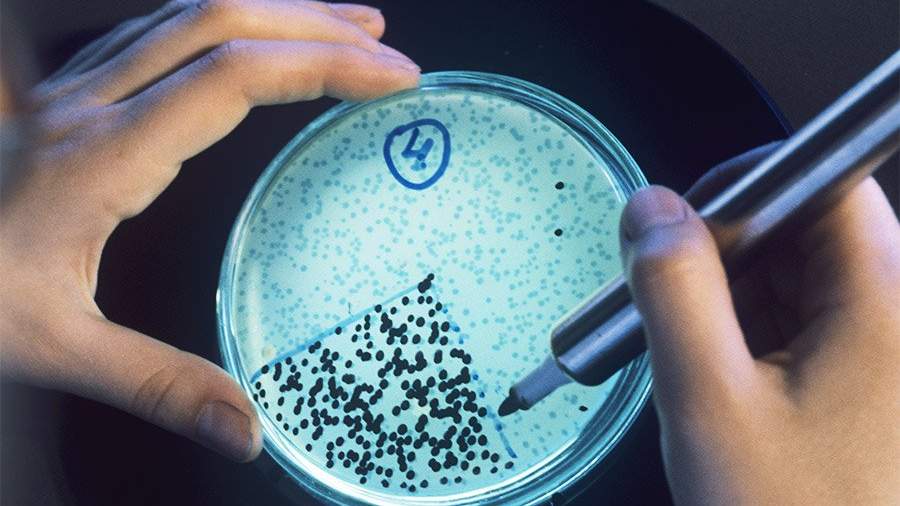

Ученые удешевили лекарство против рака
Российские ученые научились получать сырье для популярных лекарств против рака дешевым и доступным способом. Они придумали, как выращивать в биореакторах клетки тисовых деревьев, из которых добывается препарат таксол. Сейчас его получают дорогим и трудоемким методом химического синтеза либо непосредственно из деревьев, которые приходится вырубать в огромных количествах.
Биологи Института физиологии растений Российской академии наук (ИФР РАН) подобрали оптимальные условия для того, чтобы клетки тиса росли отдельно от исходных растений — в колбах и чашах Петри, затем — в биореакторах. В процессе роста они производят таксоиды — вещества, используемые для лечения различных видов раковых опухолей.
— Сотрудники нашей лаборатории получили новые штаммы разных видов тиса. Такие растения являются источниками паклитаксела, это вещество также называется «таксол». Содержащие его препараты используются при терапии различных онкологических заболеваний — например, рака легких, яичников, молочной железы. Под воздействием паклитаксела опухолевые клетки утрачивают способность к делению и гибнут, — рассказала «Известиям» научный сотрудник лаборатории культивируемых клеток ИФР РАН Мария Титова.
Как пояснила ученый, обычно для производства препаратов паклитаксела используют кору взрослых деревьев, реже хвою. При этом для получения одного килограмма лекарства может потребоваться до 10 тыс. кг коры от более чем 2–3 тыс. тисовых деревьев.
— Каждому пациенту на курс химиотерапии требуется не менее 2,5–3 г паклитаксела. Для лечения одного больного необходимо уничтожить несколько взрослых деревьев. Кроме того, получение таксола из коры или хвои требует сложной очистки с использованием современных и дорогостоящих технологий, — отметила Мария Титова.
Учитывая это, а также сезонные изменения концентрации таксоидов и высокий спрос на лекарственные препараты, во всем мире идет поиск других источников таксола.
Полученная учеными ИФР РАН культура клеток может стать альтернативным возобновляемым источником сырья для получения природных таксоидов. Технология проста: фрагменты тисового дерева — например, почки или хвою — стерилизуют и помещают в специальную питательную среду в чашках Петри. Там фрагменты дерева утрачивают признаки листа или корня, превращаются в «неопределенные клетки», которые могут дать начало новому растению.
Эти клетки заставляют делиться с помощью специально подобранной комбинации естественных гормонов растений — регуляторов роста. Зная об особенностях их действия, биотехнолог может добиваться желаемых результатов в пределах возможностей исходного растения.
— Для наших штаммов подтверждена способность к синтезу таксоидов, показана возможность управления их образованием. Изучаются способы выращивания клеток тиса в биореакторах, — рассказала Мария Титова.
С помощью разработанной технологии можно получать природное противораковое средство в промышленных объемах при небольших затратах и без уничтожения множества деревьев. Это может сделать отечественные онкопрепараты более доступными для больных.
Руководитель Центра персонализированной онкологии Сеченовского университета Марина Секачева считает исследование весьма перспективным.
— Паклитаксел, возможно, один из самых известных онкологических препаратов растительного происхождения. Противоопухолевая активность экстракта из тиса была впервые обнаружена в начале 70-х годов прошлого века. Более 25 лет понадобилось для того, чтобы эти вещества пришли в клиническую практику. Их триумф в онкологии начался с лечения рака яичников. Позже была доказана эффективность препарата при опухолях легких, молочной железы. Потребность в нем огромна. Упрощение производства сделает лекарство дешевле и доступнее, в том числе в развивающихся странах, — рассказала онколог «Известиям».
Результаты разработок ученых ИФР РАН опубликованы в «Докладах Академии наук».






